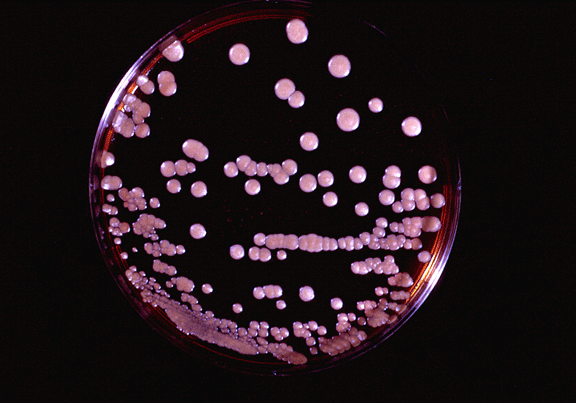
img

Pityriasis versicolor
Introduction.
Pytiriasis versicolor is a superficial fungal infection caused
by a yeast, Malassezia furfur. It causes hypopigmented lesions in dark-skinned
and tanned people by interfering with melanin production.
Summary
- Cause: Malassezia furfur
- Microscopy: Oval yeast cells, occasional end-to-end short hyphae
- Symptoms: Hypo/hyperpigmented skin lesions
- Transmission: direct contact
- Complications: folliculitis
- Pathogenesis: Superficial growth in skin; interferes with melanin
production
- Treatment: Topical azoles
References/Links
-
http://www.ak-medizin.de/pityrias/pity01.jpg
-
http://www.mycology.adelaide.edu.au/gallery/photos/malass10.html